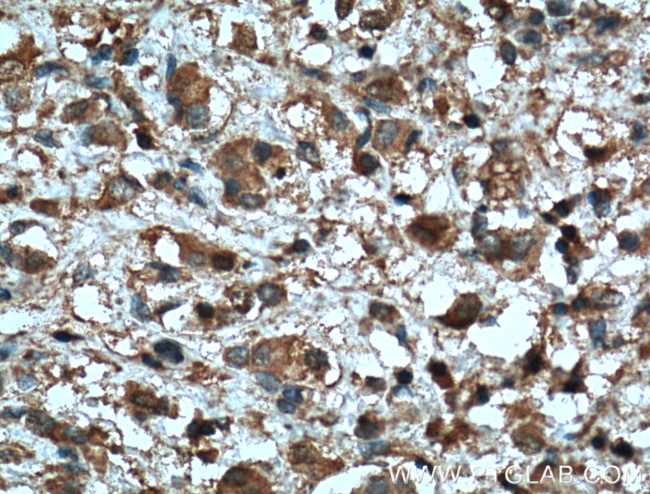
MMP2 Antibody in Immunohistochemistry (Paraffin) (IHC (P))

Search
Proteintech
MMP2 Monoclonal Antibody (2B10D1)
{{$productOrderCtrl.translations['antibody.pdp.commerceCard.promotion.promotions']}}
{{$productOrderCtrl.translations['antibody.pdp.commerceCard.promotion.viewpromo']}}
{{$productOrderCtrl.translations['antibody.pdp.commerceCard.promotion.promocode']}}: {{promo.promoCode}} {{promo.promoTitle}} {{promo.promoDescription}}. {{$productOrderCtrl.translations['antibody.pdp.commerceCard.promotion.learnmore']}}
产品信息
66366-1-IG
种属反应
已发表种属
宿主/亚型
分类
类型
克隆号
抗原
偶联物
形式
浓度
规格
纯化类型
保存液
内含物
保存条件
运输条件
产品详细信息
Immunogen sequence: IIKFPGDVA PKTDKELAVQ YLNTFYGCPK ESCNLFVLKD TLKKMQKFFG LPQTGDLDQN TIETMRKPRC GNPDVANYNF FPRKPKWDKN QITYRIIGYT PDLDPETVDD AFARAFQVWS DVTPLRFSRI HDGEADIMIN FGRWEHGDGY PFDGKDGLLA HAFAPGTGVG GDSHFDDDEL WTLGEGQVVR VKYGNADGEY CKFPFLFNGK EYNSCTDTGR SDGFLWCSTT YNFEKDGKYG FCPHEALFTM GGNAEGQPCK FPFRFQGTSY DSCTTEGRTD GYRWCGTTED YDRDKKYGFC PETAMSTVGG NSEGAPCVFP FTFLGNKYES CTSAGRSDGK MWCATTANYD DDRKWGFCPD QGYSLFLVAA HEFGHAMGLE HSQDPGALMA PIYTYTKNFR LSQDDIKGIQ ELYGASPDID LGTGPTPTLG PVTPEIC (34-469 aa encoded by BC002576)
靶标信息
MMP (matrix metalloproteinase) are proteolytic enzymes capable of degrading connective tissue components. MMP have a common mode of activation, a conserved amino acid sequence in the putative metal binding-active site region, and are inhibited by specific tissue inhibitors of metalloproteinases (TIMPs). MMPa and TIMPs play a significant role in regulating angiogenesis. MMP2 is synthesized as a 631 amino acid proenzyme which is activated by cleavage of the first 80 amino acids, and contains the basic structure of propeptide, catalytic, and hemopexin domains. The matrix metalloproteinases (MMPs) are a family of at least eighteen secreted and membrane-bound zincendopeptidases. Collectively, these enzymes can degrade all the components of the extracellular matrix, including fibrillar and non-fibrillar collagens, fibronectin, laminin and basement membrane glycoproteins. In general, a signal peptide, a propeptide, and a catalytic domain containing the highly conserved zinc-binding site characterizes the structure of the MMPs. Functionally, MMP2 is involved in tissue remodeling. Mutations in MMP-2 gene have been associated with Winchester syndrome and Nodulosis-Arthropathy-Osteolysis (NAO) syndrome. Two transcript variants encoding different isoforms of MMP-2 have been found.
仅用于科研。不用于诊断过程。未经明确授权不得转售。
生物信息学
蛋白别名: 72 kDa gelatinase; 72 kDa type IV collagenase; 72kD gelatinase; 72kD type IV collagenase; 72kDa gelatinase; 72kDa type IV collagenase; CLG 4A; Collagenase; collagenase type IV precursor; collagenase type IV-A; Gelatinase A; Gelatinase alpha; Mat; matrix metallo protease; matrix metallopeptidase 2 (gelatinase A, 72kDa gelatinase, 72kDa type IV collagenase); matrix metalloproteinase; matrix metalloproteinase 2; Matrix metalloproteinase-2; matrix metalloproteinase-II; MMP; MMP-2; MMPs; neutrophil gelatinase; Progelatinase A; TBE-1; TBE1; unnamed protein product
基因别名: CLG4; CLG4A; GelA; MMP-2; MMP-II; MMP2; MONA; TBE-1
UniProt ID: (Human) P08253, (Rat) P33436, (Mouse) P33434
Entrez Gene ID: (Human) 4313, (Pig) 397391, (Rat) 81686, (Mouse) 17390